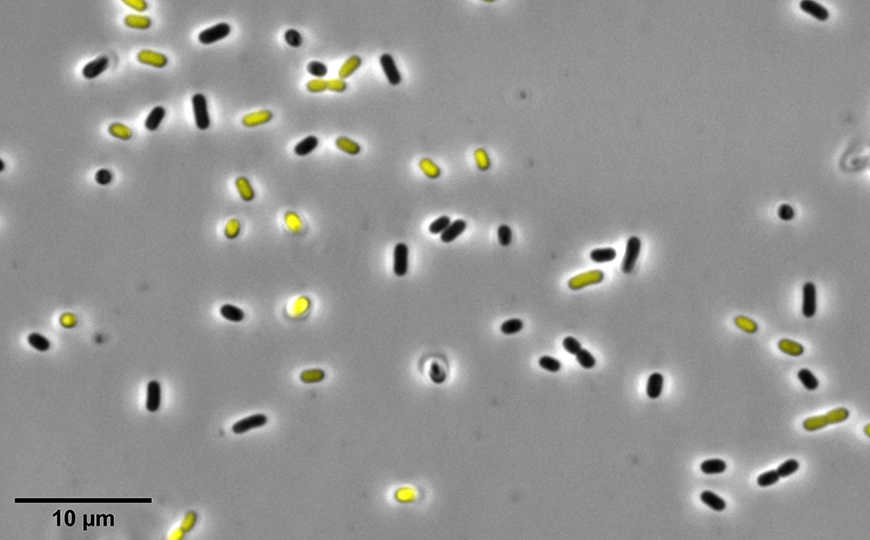

Закисление цитоплазмы помогает бактериям пережить воздействие антибиотиков
Клетки E. coli, выжившие после воздействия антибиотиков в экспериментах по направленной эволюции, накапливают мутации в комплексе I дыхательной цепи переноса электронов. Мутации нарушают танспорт протонов, что приводит к увеличению кислотности цитоплазмы и остановке синтеза белков. Из-за этого антибиотики, нацеленные на синтез белка, теряют эффективность.
Credit: KU Leuven | CC BY-SA | Пресс-релиз
Международная группа ученых обнаружила, что отклонения метаболического гомеостаза бактерий может приводить к развитию антибиотикорезистентности. В экспериментах на E. coli показано, что резистентность обеспечивают мутации в комплексе I — первом мультибелковом комплексе дыхательной цепи переноса электронов.
В предыдущей работе эти же авторы отметили, что в отдельно взятой клональной популяции бактерий при воздействии антимикробных препаратов никогда не погибает 100% клеток. Если многократно отбирать выжившие клетки, культивировать их, затем снова обрабатывать тем же препаратом, то в определенный момент чувствительными останутся только 50% всех клеток. Новая работа посвящена исследованию механизмов формирования резистентности. этому вопросу.
Ученые использовали 37 популяций лабораторного штамма E. coli, которые ранее подвергались воздействию антибиотиков амикацина, канамицина, тобрамицина или гентамицина. Для сравнения были добавлены три популяции уропатогенного штамма UTI89, которые эволюционировали в присутствии амикацина и в процессе эволюции значительно повысили резистентность к нему.
Полногеномное секвенирование 40 популяций E. coli, выполненное после завершения эволюции, выявило большое количество мутаций вОказалось, что нарушение переноса протонов приводит к увеличению кислотности цитоплазмы. При этом чем ниже были значения pH цитоплазмы, тем выше была устойчивость к антибиотикам. Протеомный анализ показал, что рост кислотности приводит к остановке синтеза белка и белкового обмена. Это делает бесполезными антимикробные препараты, такие как амикацин, для которых синтез белка служит мишенью.
Ученые также выяснили, что при повышении кислотности цитоплазмы активируется сигма-фактор RpoS — регулятор ответа на стресс. Выключение гена rpoS снижало устойчивость E. coli к антибиотикам.
Таким образом, в работе описана молекулярная основа резистентности, связанной с изменениями метаболизма бактерии. Авторы отмечают, что в экспериментах по направленной эволюции они получили множество других резистентных популяций с мутациями, затрагивающими в основном транспорт ионов или заряженных молекул, и собираются продолжить исследования.
Источник
Bram van der Bergh, et al. Mutations in respiratory complex I promote antibiotic persistence through alterations in intracellular acidity and protein synthesis // Nature Communications, published: 27 January 2022.; DOI: 10.1038/s41467-022-28141-x


 Меню
Меню





 Все темы
Все темы




 0
0












